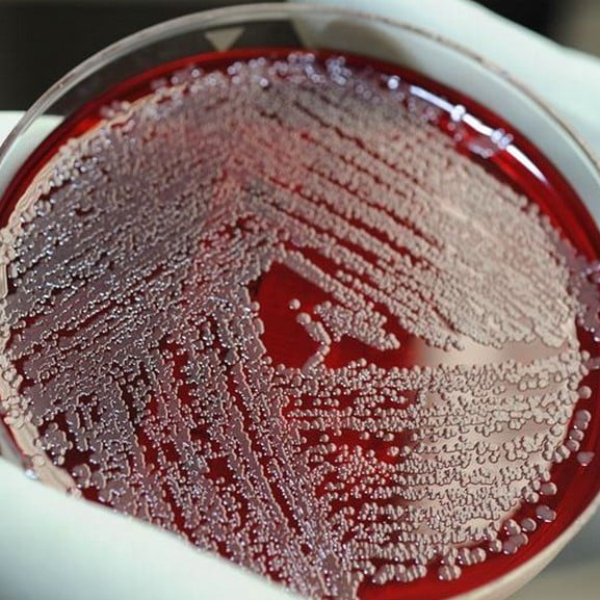

فروش سویه سودوموناس آئروژینوزا کد ATCC9027
شرکت اینترنتی تمادکالا در ارائه و فروش انواع سویههای باکتری با کیفیت منحصر به فرد و کمترین میزان قیمت، پیشرو است و همچنین آماده خدمت رسانی به تمام مشتریان میباشد. اطلاعات سویه سودوموناس آئروژینوزا کد ATCC9027 را میتوانید در بخش بعدی مشاهده کنید. سویه باکتریایی در واقع سلولهای باکتریایی با ژنتیکی تقریبا یکسان هستند. سویه سودوموناس آئروژینوزا کد ATCC 9027 از سویه استاندارد تعیین شده توسط سازمان توسعه استانداردهای ATCC است. سویه ای از باکتری سودوموناس آئروژینوزا است که برای تحقیقات علمی، کنترل کیفیت در آزمایشگاهها، و تستهای مختلف مربوط به سودوموناس آئروژینوزا به ویژه در علم بیوانفورماتیک استفاده میشود.
سویه ATCC 9027 به دلیل ویژگیهای استاندارد و قابل پیشبینی خود، یک ابزار ارزشمند در تحقیقات و آزمایشهای مربوط به این باکتری است. سودوموناس آئروژینوزا یک باکتری گرم منفی است که به طور طبیعی در محیط و در خاک و آب وجود دارد. سودوموناس آئروژینوزا شایع ترین گونه سودوموناس در عفونت های انسانی است. این باکتری منجر به عفونت در خون، ریه و سایر قسمت های بدن پس از جراحی می شود. سودوموناس آئروژینوزا یک باکتری فعال است که راه های جدیدی برای جلوگیری از اثرات آنتی بیوتیک های مورد استفاده برای درمان عفونت ها را پیدا می کند. این باکتری در بیمارانی دارای نقص سیستم ایمنی مانند بیماران مبتلا به سوختگیهای شدید، سرطان و ایدز خطرناک است. سویه ATCC 9027 برای استفاده در تحقیقات آزمایشگاهی بوده و هیچ گونه استفاده درمانی و تشخیصی از آن مناسب نیست.
ویژگیهای سویه سودوموناس آئروژینوزا کد ATCC9027
- باکتری گرم منفی و شکل سلولی میلهای
- قابلیت تحرک با فلاژلا
- کاتالاز و اکسیداز مثبت
- تولید پیوسیانین (رنگ آبی-سبز)
- توانایی رشد در محیطهای مرطوب و فقیر
کاربردهای سویه سودوموناس آئروژینوزا کد ATCC9027
- کاربرد در آزمایشهای محیط کشت، کنترل کیفیت، آزمایشهای دارویی، آزمایش افزایش رشد، پایش محیطی، تولید سورفکتانت رامنولیپید و به عنوان میکروارگانیسم آزمایشی
- در آزمایش شناسایی و شمارش میکروبی و آزمایش استریلیتی
- برای بررسی ویژگیهای مختلف باکتری سودوموناس آئروژینوزا از جمله مقاومت آنتیبیوتیکی، آزمایش پایداری میکروبی، تولید سموم، و رشد در شرایط مختلف
- کاربرد اصلی در آزمون ضدعفونیکنندهها، داروهای ضد میکروبی و آنتیسپتیکها برای بررسی اثربخشی از نظر توانایی از بین بردن باکتری سودوموناس آئروژینوزا
- کنترل کیفی و کنترل آلودگی در صنایع دارویی و آرایشی
- بسیار مفید و کاربردی برای تست های چالش Challenge Test به دلیل توانایی بالای برای زندهماندن در محیطهای سخت و مرطوب
- به عنوان یک کنترل مثبت در آزمایشها و تستهای مربوط به سودوموناس آئروژینوزا برای بررسی درستی و نتایج قابل اعتماد آزمایشها
- برای ارزیابی کیفیت محیطهای کشت و اطمینان از رشد مناسب باکتری در محیطهای مختلف
- جهت مطالعه پایداری فرمولاسیونها و آزمایش های مربوط به آب همراه با سایر سویهها
کاربرد معمول سویهها
- مطالعه ژن ها، جهش ها و مقاومت دارویی
- برای تولید واکسن انتی بیوتیک
- تشخیص بیماری و کشت باکتری در آزمایش های تشخیص طبی
- مطالعه اپیدمیولوژی
محیطهای کشت رایج
- Cetrimide agar (اختصاصی سودوموناس)
- Tryptic Soy Agar (TSA)
- Nutrient agar
- MacConkey agar (بدون تخمیر لاکتوز)
خرید سویه سودوموناس آئروژینوزا کد ATCC9027
شما می توانید سویه سودوموناس آئروژینوزا کد ATCC9027 را هم اکنون با بهترین کیفیت، مناسب ترین قیمت و از طریق تلفنی و یا ثبت درخواست در سایت تمادکالا خریداری نمایید.